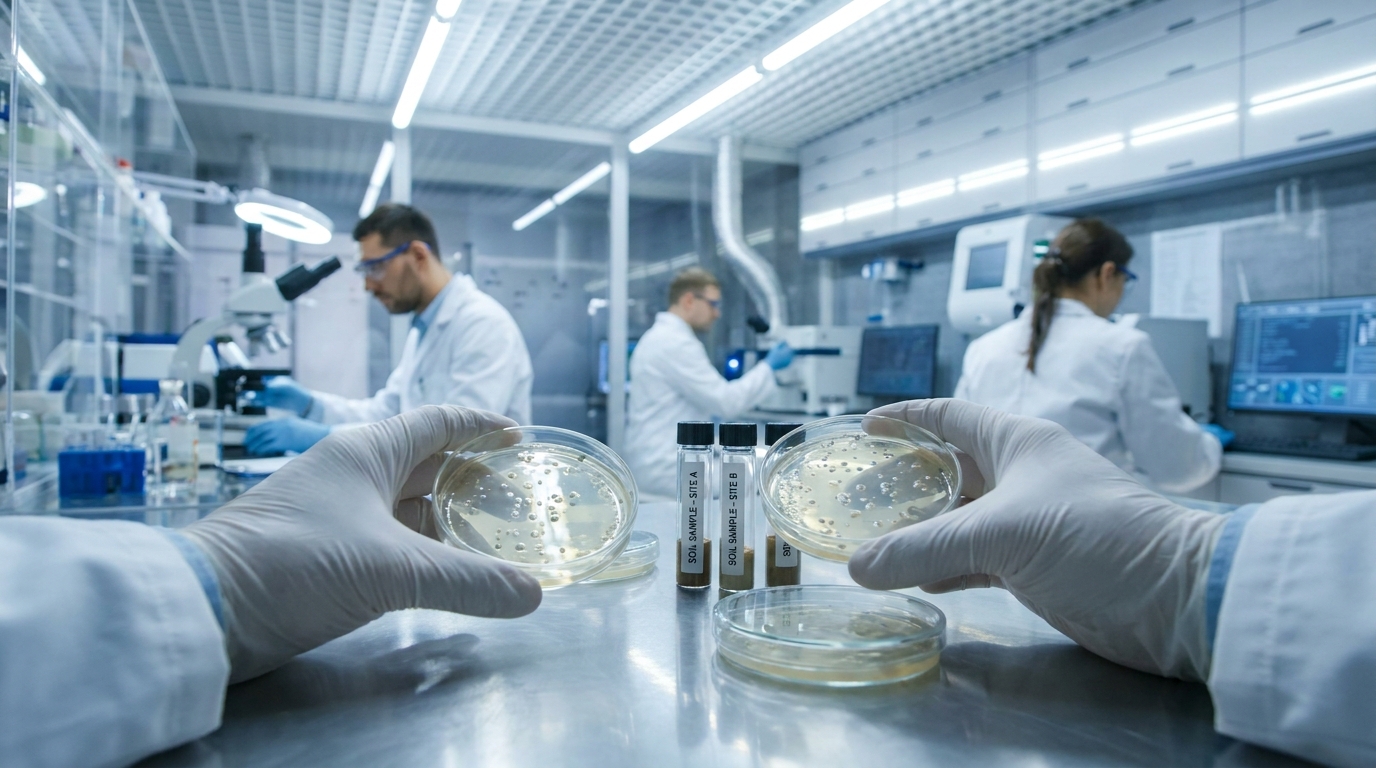

Des fientes d’oies transformées en protéines et engrais : la découverte surprenante d’une équipe de chercheurs
Auteur: Mathieu Gagnon
L’invasion printanière et le défi environnemental

Les observations d’oies sont difficiles à manquer lors de la saison printanière. Vous les voyez voler dans le ciel, puis vous remarquez ce qu’elles laissent derrière elles sur le sol. Les parcs, les terrains de sport et les espaces ouverts peuvent rapidement se retrouver couverts de fientes.
Cette situation génère une odeur désagréable et possède la capacité d’affecter la santé des écosystèmes locaux. Il y a pourtant une autre dimension à ces déjections qui dépasse le simple désagrément. Ce que les promeneurs tentent habituellement d’éviter pourrait avoir une véritable utilité pratique.
Les scientifiques ont commencé à examiner les déchets d’oies sous un angle radicalement différent, en posant une question simple. L’objectif est de savoir s’il est possible de transformer cette matière en une ressource précieuse au lieu de la traiter uniquement comme un problème urbain.
La mouche soldat noire, une alliée inattendue

Les chercheurs ont adopté une approche différente en observant un insecte qui effectue déjà ce type de travail dans la nature. La mouche soldat noire est spécifiquement connue pour sa capacité à gérer les déchets organiques.
Ses larves se nourrissent de matières résiduelles et les décomposent tout au long de leur croissance. Au cours de ce processus naturel, elles transforment ces déchets bruts en protéines et en nutriments capables d’être réutilisés.
L’équipe de recherche, dirigée par Rassim Khelifa à l’Université Concordia, a voulu vérifier si ces insectes pouvaient s’adapter et gérer les fientes d’oies. « Nous voulions voir si la mouche soldat noire, une espèce non indigène qui est déjà largement récoltée industriellement, pouvait être utilisée pour transformer les déchets d’oies en biens de valeur comme des protéines et de l’engrais », a déclaré Khelifa. « La réponse est oui ; elle le peut. »
Des tests entre le terrain et le laboratoire
Les chercheurs ont d’abord procédé à une évaluation précise pour déterminer la quantité de déchets laissés par les oies dans les zones urbaines. Ils ont étudié 11 sites répartis à travers le sud du Québec et de l’Ontario. Les résultats ont montré un lien direct entre le nombre d’oiseaux et la quantité de fientes, révélant que les volées les plus importantes entraînaient une contamination accrue des espaces publics.
En laboratoire, ils ont nourri les larves de mouches soldats noires selon trois types de régimes distincts. Le premier consistait en un mélange standard habituellement utilisé pour la recherche. Le deuxième combinait ce même mélange avec des excréments d’oies. Le troisième était uniquement composé de ces fientes. Les insectes ont survécu avec les trois régimes, avec des différences claires dans leur développement.
Les larves nourries avec un mélange d’aliments ont grandi plus rapidement, ont affiché un taux de survie plus élevé et ont traité les déchets avec une efficacité supérieure. Celles nourries uniquement de fientes d’oies ont tout de même consommé plus de la moitié de la matière disponible, bien qu’elles aient grandi plus lentement pour devenir des adultes de plus petite taille. Les résultats indiquent que les déchets d’oies seuls suffisent à maintenir le processus en activité, même si les conditions ne sont pas idéales.
Le rôle essentiel des microbes naturels

L’équipe a vérifié si le traitement préalable des fientes modifiait les résultats obtenus lors de la digestion. Certains échantillons ont été stérilisés à l’aide de chaleur et de pression dans le but d’éliminer les bactéries, un processus technique appelé autoclavage.
Les larves nourries avec ces déchets stérilisés ont présenté des performances nettement inférieures. Elles ont consommé une quantité moindre de nourriture, ont grandi à un rythme plus lent et ont eu une durée de vie plus courte une fois parvenues au stade adulte.
Cette observation souligne un point particulièrement intéressant concernant la digestion des insectes. Les microbes naturels présents dans les fientes d’oies aident concrètement au développement des larves. Cela démontre que les bactéries, souvent perçues comme un problème sanitaire, se révèlent utiles lorsqu’elles se trouvent dans des conditions appropriées.
Du déchet animal à l’engrais végétal

Le cycle de transformation implique une étape supplémentaire après l’intervention des insectes. Une fois que les larves se sont nourries, elles laissent derrière elles une matière résiduelle appelée « frass ». Ce sous-produit est particulièrement riche en nutriments et s’utilise efficacement comme engrais.
Les chercheurs ont testé ce frass sur les lentilles d’eau, une petite plante aquatique caractérisée par sa croissance rapide. Cette espèce végétale est couramment employée dans l’alimentation animale ainsi que dans le traitement des eaux.
Les résultats de cette expérience se sont démarqués. Les lentilles d’eau cultivées avec cet engrais ont produit un rendement supérieur de 32 % par rapport aux plantes cultivées avec une solution nutritive standard. Les plantes ont développé des racines plus courtes, signe d’un accès facilité aux nutriments. En termes simples, le frass a permis aux plantes de croître solidement sans avoir besoin de s’étirer pour trouver leur nourriture.
Vers une gestion circulaire des espaces urbains

Cette approche crée une boucle de transformation où les déchets deviennent une ressource utile. Les fientes d’oies nourrissent les insectes, qui produisent à leur tour de la matière favorisant la croissance des plantes. Chaque étape ajoute de la valeur au lieu de générer davantage de rebuts.
Cette méthode offre des avantages pratiques tangibles pour les espaces urbains. Retirer les fientes des parcs améliore les conditions sanitaires et réduit les risques de dommages environnementaux, comme la surcharge en nutriments dans les systèmes d’eau. Ce processus produit simultanément des protéines destinées à l’alimentation animale et des engrais pour la croissance végétale.
Des travaux supplémentaires restent nécessaires avant un déploiement à grande échelle. L’idée demeure simple et pratique. Elle offre aux gestionnaires municipaux, aux agriculteurs et aux communautés éloignées une méthode à bas coût pour traiter des déchets qui finissent habituellement ignorés.
Les fientes d’oies sous les semelles ne seront jamais les bienvenues, mais elles n’ont pas à rester inutiles. Avec les outils adéquats et une réflexion créative, un élément repoussant devient une partie intégrante d’un système fonctionnel. La nature fonctionne déjà par cycles, et cette recherche, publiée dans le Journal of Environmental Management, illustre comment les systèmes humains peuvent adopter ce même modèle. Au lieu de considérer les déchets comme la fin de la chaîne, ils peuvent marquer le début de quelque chose de nouveau.
Selon la source : earth.com